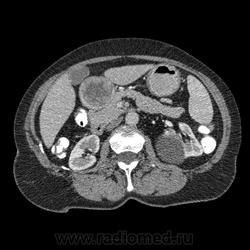

Пол пациента:
Тип патологии:
Область исследования:
Методы исследования:
- https://radiomed.ru/sites/default/files/styles/case_slider_image/public/user/16726/img-0002-00133.jpg?itok=AvLSD3wV
- https://radiomed.ru/sites/default/files/styles/case_slider_image/public/user/16726/img-0002-00135.jpg?itok=AtIbeLVZ
- https://radiomed.ru/sites/default/files/styles/case_slider_image/public/user/16726/img-0002-00139.jpg?itok=jgyeqg1q
- https://radiomed.ru/sites/default/files/styles/case_slider_image/public/user/16726/img-0002-00147.jpg?itok=i51NtZT2
- https://radiomed.ru/sites/default/files/styles/case_slider_image/public/user/16726/img-0002-00150.jpg?itok=AU5ovLZG
- https://radiomed.ru/sites/default/files/styles/case_slider_image/public/user/16726/img-0002-00153.jpg?itok=viME6vqE
- https://radiomed.ru/sites/default/files/styles/case_slider_image/public/user/16726/img-0002-00155.jpg?itok=xoLnCkR7
- https://radiomed.ru/sites/default/files/styles/case_slider_image/public/user/16726/img-0002-00158.jpg?itok=S6ZyvAXQ
- https://radiomed.ru/sites/default/files/styles/case_slider_image/public/user/16726/img-0002-00162.jpg?itok=Q9KVbIRL
- https://radiomed.ru/sites/default/files/styles/case_slider_image/public/user/16726/img-0002-00172.jpg?itok=Wqx7NrLz
- https://radiomed.ru/sites/default/files/styles/case_slider_image/public/user/16726/img-0002-00183.jpg?itok=h8ojx3HY
- https://radiomed.ru/sites/default/files/styles/case_slider_image/public/user/16726/img-0001-00175.jpg?itok=M8Xw-Nih
- https://radiomed.ru/sites/default/files/styles/case_slider_image/public/user/16726/img-0001-00173.jpg?itok=GaqQzlss
- https://radiomed.ru/sites/default/files/styles/case_slider_image/public/user/16726/img-0001-00186.jpg?itok=e1wgGZ5l
- https://radiomed.ru/sites/default/files/styles/case_slider_image/public/user/16726/img-0001-00189.jpg?itok=PhNkAk2w
- https://radiomed.ru/sites/default/files/styles/case_slider_image/public/user/16726/img-0001-00191.jpg?itok=Ak7kQksh
- https://radiomed.ru/sites/default/files/styles/case_slider_image/public/user/16726/img-0001-00196.jpg?itok=jY_hc1ZE
- https://radiomed.ru/sites/default/files/styles/case_slider_image/public/user/16726/img-0001-00201.jpg?itok=jeX56NPa
- https://radiomed.ru/sites/default/files/styles/case_slider_image/public/user/16726/img-0001-00207.jpg?itok=FgGkZgDL
- https://radiomed.ru/sites/default/files/styles/case_slider_image/public/user/16726/img-0001-00209.jpg?itok=iUUEDVn3
- https://radiomed.ru/sites/default/files/styles/case_slider_image/public/user/16726/img-0001-00216.jpg?itok=xa9NJrHP
- https://radiomed.ru/sites/default/files/styles/case_slider_image/public/user/16726/img-0001-00224.jpg?itok=4TjNAb5l
- https://radiomed.ru/sites/default/files/styles/case_slider_image/public/user/16726/img-0001-00236.jpg?itok=AwCdylkc
- https://radiomed.ru/sites/default/files/styles/case_slider_image/public/user/16726/img-0002-00186.jpg?itok=J75oHGH6
- https://radiomed.ru/sites/default/files/styles/case_slider_image/public/user/16726/img-0002-00190.jpg?itok=K6a3LMZN
- https://radiomed.ru/sites/default/files/styles/case_slider_image/public/user/16726/img-0002-00192.jpg?itok=N6fH2cqn
- https://radiomed.ru/sites/default/files/styles/case_slider_image/public/user/16726/img-0002-00196.jpg?itok=GS6beHzh
- https://radiomed.ru/sites/default/files/styles/case_slider_image/public/user/16726/img-0002-00200.jpg?itok=sdWZ3zj3
- https://radiomed.ru/sites/default/files/styles/case_slider_image/public/user/16726/img-0002-00203.jpg?itok=6V3S20DN
- https://radiomed.ru/sites/default/files/styles/case_slider_image/public/user/16726/img-0002-00210.jpg?itok=zzySLCJq
- https://radiomed.ru/sites/default/files/styles/case_slider_image/public/user/16726/img-0002-00217.jpg?itok=-n6ncIAO
ID:24488

Впечатление, что дуля эта вне головки п.ж., интрамурально в луковице, что ли... тогда возможно GIST, но надо дайком. Утолщение подслизистой в антральном отделе желудка, не удается проследить переход от желудка к 12-перстной((. Внутрипросветно/внутристеночно - не разобрать. 1 фаза?
Клинику! Есть ли признаки высокой тонкокишечной непроходимости, что при ФЭГДС в 12-перстной - туда удалось пройти или нет? ААА! Одни вопросы))))
В-общем, варианты такие без дайкомов: пролапс слизистой в 12перстную, безоар, внутрипросветный дивертикул, гастроинтерстинальная опухоль. И большие сомнения, что это в головке п.ж. - оно отделено от неё тонким слоем жировой клетчатки
https://www.youtube.com/channel/UCBGxoBUOqUT_bFhSeUgtWEw
Фаз было 3. Видео не выставлял прошлый раз пришел ответ из сайта что видео не работает на сайте Идет накопление контраста в нативе в центре +2+4 по периферии +32+34 .в артериальную +20 и +65 +70 соответственно.
Что оно копит - бог с ним... если это пролапс слизистой, то суммация стенок. Безоар бы не копил. Напрягает отек слизистой в антрале... Это должно быть скорее внутри просвета кишки, т.к. оттесняет газ в 12-перстной на периферию. Без дайкомов больше ничем не могу, извините. Подождём мнения коллег.
https://www.youtube.com/channel/UCBGxoBUOqUT_bFhSeUgtWEw
Видео не работает. Повторяю, не работает). И Ваш случай становится невидимым... Эх... Пришлось удалить видео.
Дайкомы (dicom) надо копировать в папку, заархивировать, закачать на файлообменник и дать сюда ссыль.
Видео (wmv) тут:
http://files.mail.ru/MMC9DD
http://files.mail.ru/FVBBO9
http://files.mail.ru/S3CW12
Как мне видится - пролапс слизистой желудка в 12-перстную. А мнения коллег что-то нетути...
https://www.youtube.com/channel/UCBGxoBUOqUT_bFhSeUgtWEw
А что растет из левой почки? Может оно же и желудок сдавливает?
Хочешь сделать что-то нормально - сделай это сам!
Это расширение всей 12- перстной кишки (стаз).
Н.Б.
Ошибаетесь.
Посмотрите видео, только верхняя треть и расширена.
https://www.youtube.com/channel/UCBGxoBUOqUT_bFhSeUgtWEw